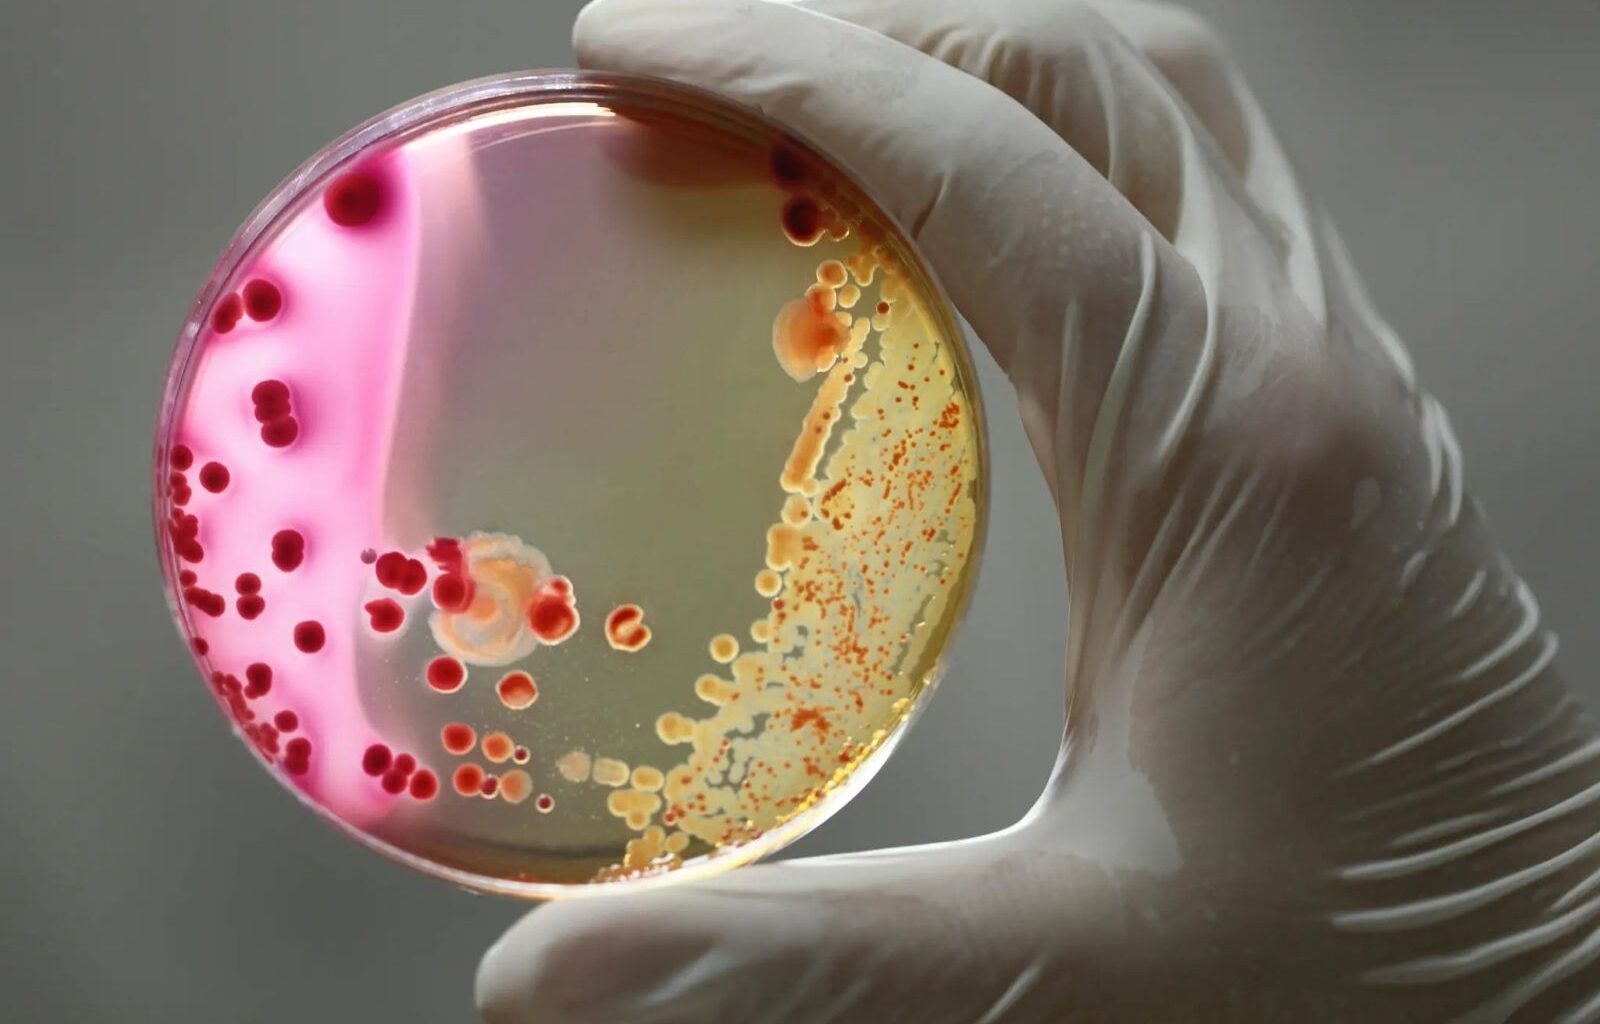
Bacteriile devin tot mai puternice, iar antibioticele tot mai slabe. Una din șase infecții bacteriene este rezistentă la tratament

În cel mai amplu raport publicat până acum privind rezistența la antibiotice, Organizația Mondială a Sănătății (OMS) avertizează că „rezistența antimicrobiană este răspândită, în creștere și inegal distribuită”, iar eficacitatea tratamentelor de primă alegere „este tot mai compromisă”.
În Europa, rezistența la antibiotice crește îngrijorător
Raportul privind supravegherea rezistenței la antibiotice se bazează pe mai mult de 23 de milioane de infecții bacteriene, analizate în 104 țări între 2016 și 2023. Rezultatele arată că aproximativ 17% dintre infecțiile confirmate sunt cauzate de bacterii care nu mai răspund la antibioticele uzuale.
„Rezistența bacteriilor la medicamentele salvatoare de vieți este critic de ridicată și în creștere, în special în țările cu resurse limitate”, atrage atenția dr. Yukiko Nakatani, director general adjunct al OMS, în prefața raportului.
Potrivit analizei OMS, rezistența este cea mai mare în Asia de Sud-Est și Orientul Mijlociu, unde aproape o treime dintre infecțiile raportate sunt rezistente.
În Africa, infecțiile de sânge cauzate de bacterii precum E. coli și Klebsiella pneumoniae prezintă rate de rezistență ce depășesc 70%, în timp ce în Europa media este de 10–17%, dar cu tendințe ascendente în țările din estul continentului, inclusiv România.
Bacterii comune, tot mai periculoase
Escherichia coli și Klebsiella pneumoniae sunt printre principalii agenți ai infecțiilor rezistente la antibiotice, cea din urmă fiind una dintre cele mai periculoase cauze ale infecțiilor spitalicești grave, deși trăiește adesea în organism – în intestin, nas sau gât – fără să provoace boală.
România, parte a rețelei europene EARS-Net, care monitorizează rezistența bacteriană la nivelul spitalelor europene, și a sistemului global OMS GLASS, destinat supravegherii rezistenței la antibiotice la scară mondială, este inclusă în estimările regionale din raport. Europa are, în ansamblu, niveluri mai scăzute decât alte regiuni, dar cu tendințe de creștere pentru unele bacterii și antibiotice-cheie.
Rezistență în creștere la antibiotice-cheie
Printre aceste combinații se numără Klebsiella pneumoniae rezistentă la imipenem (un antibiotic puternic, folosit ca ultimă opțiune) în infecțiile urinare, cu o creștere anuală estimată de 29,4% între 2018 și 2023.
De asemenea, toate speciile din genul Salmonella au dobândit rezistență la ciprofloxacină, în creștere cu 36,2% în Europa față de doar 4,9% în Pacificul de Vest. Iar Klebsiella pneumoniae rezistentă la cefotaxim (o cefalosporină de generația a treia) înregistrează o rată medie de rezistență de 17,7% la nivel european.
„Una din șase infecții bacteriene este rezistentă la tratament”
Analiza datelor indică faptul că „una din șase infecții bacteriene este rezistentă la tratament” astăzi, rezistența la antibiotice fiind deja asociată cu peste un milion de decese anual la nivel mondial.
OMS descrie această evoluție ca o „sindemie”, o combinație între rezistența bacteriană și slăbiciunea sistemelor de sănătate, care afectează disproporționat țările cu venituri mici și mijlocii. În multe dintre acestea, doar 1-2% dintre laboratoare pot efectua teste microbiologice complete, ceea ce duce la tratamente empirice și la utilizarea excesivă a antibioticelor puternice.
„Rezistența antimicrobiană depășește progresele medicinei moderne, amenințând sănătatea familiilor din întreaga lume. Trebuie să folosim antibioticele responsabil și să asigurăm acces la tratamente de calitate și la vaccinuri”, a declarat Tedros Adhanom Ghebreyesus, directorul general al OMS, luni, odată cu publicarea raportului.
Planul OMS pentru controlul rezistenței
OMS cere măsuri urgente pentru a limita răspândirea rezistenței la antibiotice până în anul 2030, subliniind că „până atunci cel puțin 70% din consumul total de antibiotice ar trebui să provină din categoria Access, în conformitate cu Declarația Politică a ONU din 2024 privind rezistența antimicrobiană”. Această categorie include antibioticele de primă alegere, cu spectru restrâns, considerate esențiale și mai puțin susceptibile de a genera rezistență.
Raportul arată că „reducerea utilizării antibioticelor din grupul Watch – care cuprind medicamente cu spectru larg și risc crescut de a genera rezistență – și promovarea celor din grupul Access sunt strategii esențiale pentru limitarea rezistenței antimicrobiene”.
„Infecțiile obișnuite ar putea redeveni netratabile”
OMS solicită, de asemenea, „investiții susținute în diagnosticare, cercetare și dezvoltarea de medicamente noi”, precum și aplicarea unei „abordări coordonate de tip «One Health», care să conecteze sănătatea umană, animală și de mediu pentru a combate eficient rezistența antimicrobiană”.
„Fără acțiuni urgente și susținute, infecțiile obișnuite ar putea redeveni netratabile”, punând în pericol progresele medicinei moderne, atrage atenția Organizația Mondială a Sănătății.